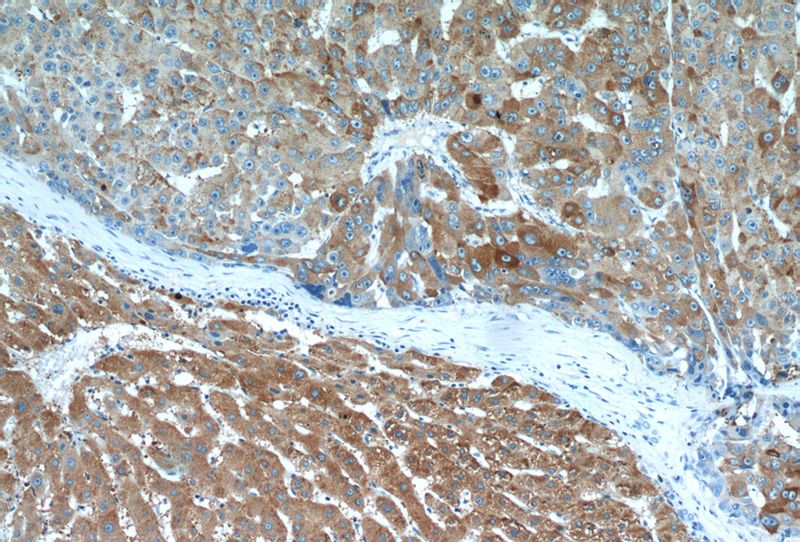
Immunohistochemical of paraffin-embedded human liver cancer using Catalog No:114562(RBP4 antibody) at dilution of 1:50 (under 10x lens)

-
Product Name
RBP4 antibody
- Documents
-
Description
RBP4 Rabbit Polyclonal antibody. Positive IHC detected in human liver cancer tissue, mouse liver tissue. Positive WB detected in human plasma tissue, human liver tissue, mouse liver tissue, rat liver tissue. Observed molecular weight by Western-blot: 23 kDa
-
Tested applications
ELISA, IHC, WB
-
Species reactivity
Human,Mouse,Rat; other species not tested.
-
Alternative names
Plasma retinol binding protein antibody; PRBP antibody; RBP antibody; RBP4 antibody; Retinol binding protein 4 antibody
-
Isotype
Rabbit IgG
-
Preparation
This antibody was obtained by immunization of RBP4 recombinant protein (Accession Number: NM_006744). Purification method: Antigen affinity purified.
-
Clonality
Polyclonal
-
Formulation
PBS with 0.1% sodium azide and 50% glycerol pH 7.3.
-
Storage instructions
Store at -20℃. DO NOT ALIQUOT
-
Applications
Recommended Dilution:
WB: 1:500-1:5000
IHC: 1:20-1:200
-
Validations
Immunohistochemical of paraffin-embedded human liver cancer using Catalog No:114562(RBP4 antibody) at dilution of 1:50 (under 10x lens)

Immunohistochemical of paraffin-embedded human liver cancer using Catalog No:114562(RBP4 antibody) at dilution of 1:50 (under 40x lens)

human plasma tissue were subjected to SDS PAGE followed by western blot with Catalog No:114562(RBP4 Antibody) at dilution of 1:1000
-
Background
RBP4 (retinol-binding protein 4) is a carrier protein that transports vitamin A (retinol) from the liver to the peripheral tissues. Synthesized primarily by hepatocytes and adipocytes as a 21 kDa non-glycosylated protein, RBP4 is secreted into the circulation as a retinol-RBP4 complex. In plasma the RBP4-retinol complex is bound to transthyretin (TRR), which prevents prevent kidney filtration. Two truncated forms of RBP4, RBP4-L (truncated at Leu-183) and RBP4-LL (truncated at Leu-182 and Leu-183), exist by proteolytic process. RBP4-L and RBP4-LL, which do not bind TTR, are normally excreted into the urine but accumulate in the serum during renal failure. Urinary RBP4 has been reported as marker for glomerular disease. RBP4 also was identified as an adipokine that elevated in some insulin-resistant states. Measurement of serum RBP4 could be used to assess the risk of insulin resistance, type 2 diabetes, obesity, and cardiovascular disease. (18752671, 16034410)
-
References
- Lu CM, Wu YJ, Chen CC. Identification of low-abundance proteins via fractionation of the urine proteome with weak anion exchange chromatography. Proteome science. 9:17. 2011.
Related Products / Services
Please note: All products are "FOR RESEARCH USE ONLY AND ARE NOT INTENDED FOR DIAGNOSTIC OR THERAPEUTIC USE"
